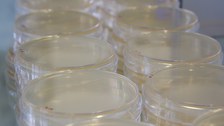
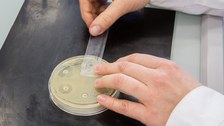

ANTIVERSA
Table of contents
Biodiversity as an ecological barrier for the spread of clinically relevant antibiotic resistance in the environment
Antimicrobial resistance (AMR) is one of the largest health-related issues world-wide. The capacity of microorganisms (bacteria, viruses, parasites, fungi and other pathogens) to develop resistance to the drugs used to fight them is exponentially increasing. Nowadays, many surface waters and soils are occasionally or chronically polluted by antimicrobial compounds. At the same time, antibiotic resistant bacteria (ARBs) and antibiotic resistant genes (ARGs) also spread into the environment, e.g. from manure and livestock facilities as well as from treated and untreated urban, hospital and industrial wastewater. The role of the environment in promoting or hindering the dissemination of resistance through pathogenic and non-pathogenic bacteria is currently under scientific scrutiny. The ANTIVERSA project consortium aims to study whether highly diverse aquatic and terrestrial ecosystems could prevent or delay the diffusion of AMR.
Check out our latest publications and further project material!
About the Project
ANTIVERSA is project of an European Consortium, composed of teams from seven countries and coordinated by the Technical University of Dresden (TUD).
The main objective is understand the impact of diversity on the invasion of natural microbial communities (microbiomes of aquatic stream biofilms and terrestrial soils) by ARBs, ARGs and their associated mobile genetic elements (MGEs). Aquatic biofilms and soil microbiomes of contrasting diversity will be exposed to extracellular DNA, transducing phages or resistant bacteria of anthropogenic origin in experiments following standardised procedures to be obtain comparable results from all consortium countries. Additionally, selected aquatic and terrestrial sites with different level of biodiversity from all consortium countries will be monitored over time for their biodiversity and abundance in ARGs and ARBs, under the hypothesis to find a negative correlation between the biodiversity and the abundance of antibiotic resistance. Overall, the ANTIVERSA project stresses the importance of studying the nexus between biodiversity and the antibiotic resistance with the final goal of preserving natural ecosystems services and to help develop management practices and regulations to maintain water and soil quality.

© Giulia Gionchetta

© Giulia Gionchetta

© Giulia Gionchetta

© Cristian Coman

© Cristian Coman

© Cristian Coman

© Uchechi Okoroafor

© Uchechi Okoroafor

© Uchechi Okoroafor
Follow us

© Luise Richter

© Luise Richter

© Luise Richter
Team
ANTIVERSA is project of an European Consortium, composed of teams from seven countries.
Prof. Thomas Berendonk (coordinator) & Team, Technische Universität Dresden (TUD) , Germany send email
- Impact of ecological and evolutionary processes on genetic and eco-physiological diversity in aquatic systems
- Aquatic ecotoxicology - effect analysis and risk assessment of environmental chemicals
- Structure and function of lakes and reservoirs ecosystems and their control, especially under the influence of climate change
- Interactions between biological colonisation and function of rivers and streams
- Mathematical models for water quality management and hypothesis testing
- Variability and evolution of antibiotic resistances in the environment
Dr. Fiona Walsh & Ms Uchechi Okoroafor, National University of Ireland, Maynooth, Co Kildare, Ireland send email
- antimicrobial resistance from a One Health perspective (environment, animal, and human health)
- impact of human and animal activities on the resistome and microbiome of soil, plants, and water
Dr. Christophe Merlin & Team, The CNRS, the University of Lorraine and the Laboratoire de Chimie Physique et Microbiologie pour les Matériaux et l’Environnement (LCPME), France send email
- bacterial genetics
- mobile genetic elements
- environmental microbiology
- antibiotic resistance
- horizontal gene transfer
- antibiotic collateral effects
Dr. Markus Wögerbauer & Team, Austrian Agency for Health and Food Safety (AGES), Vienna, Austria send mail
Dr. Norbert Kreuzinger & Team, TU Wien, Institute for Water Quality and Resource Management, Vienna, Austria send email
Dr. Helmut Bürgmann & Team, Swiss Federal Institute of Aquatic Science and Technology (Eawag), Kastanienbaum, Switzerland send email
Dr. Cristian Coman & Team, Institute of Biological Research Cluj (INCDSB), Cluj-Napoca, Romania send mail
- Microbial biodiversity and ecology
- spread of antibiotic resistance
- anthropic impact
Prof. Magdalena Popowska & Team, University of Warsaw, Institute of Microbiology, Warsaw, Poland send mail

Prof. Thomas Berendonk (coordinator) & Team, Technische Universität Dresden (TUD) , Germany © TUD

Dr. Fiona Walsh & Ms Uchechi Okoroafor, National University of Ireland, Maynooth, Co Kildare, Ireland © Maynooth University

Dr. Christophe Merlin & Team, The CNRS, the University of Lorraine and the Laboratoire de Chimie Physique et Microbiologie pour les Matériaux et l’Environnement (LCPME), France © univ-lorraine

Dr. Helmut Bürgmann & Team, Swiss Federal Institute of Aquatic Science and Technology (Eawag), Kastanienbaum, Switzerland © eawag

Dr. Markus Wögerbauer, Austrian Agency for Health and Food Safety (AGES), Vienna, Austria © AGES

Dr. Norbert Kreuzinger, TU Wien, Institute for Water Quality and Resource Management Vienna, Austria © TU Wien

Dr. Cristian Coman & Team, Institute of Biological Research Cluj, (INCDSB), Cluj-Napoca, Romania © INCDSB

Prof. Magdalena Popowska & Team, University of Warsaw, Institute of Microbiology, Warsaw, Poland © zwykly

Stadtentwässerung Dresden, Germany © Stadtentwässerung Dresden
Funding
The project is part of BiodivERsA and funded by
- Bundesministerium für Bildung und Forschung (Germany, funding nr. 01LC1904A)
- Environmental Protection Agency (Ireland)
- Agence Nationale de la Recherche (France)
- Fonds zur Förderung der Wissenschaftlichen Forschung (Austria)
- Swiss National Science Foundation (Switzerland)
- Executive Unit for Financing Higher Education, Research, Development and Innovation (Romania)
- National Science Centre (Poland)
- Stadtentwässerung Dresden (Germany)
- The European Commission Horizon 2020 programme
Publications
- Goryluk-Salmonowicz, A, & Popowska, M (2022) Factors promoting and limiting antimicrobial resistance in the environment–Existing knowledge gaps. Frontiers in Microbiology, 13. doi: 10.3389/fmicb.2022.992268
-
Kampouris I, Klümper U, Kramer L, Sorum H, Wedekind H, Berendonk TU (2022)
Dissemination of antibiotic resistance in antibiotic-free recirculating aquaculture systems. Journal of Hazardous Materials Advances. https://doi.org/10.1016/j.hazadv.2022.100201
- Kampouris ID, Agrawal S, Orschler L, Cacace D, Kunze S, Berendonk TU, Klümper U (2021) Antibiotic resistance gene load and irrigation intensity determine the impact of wastewater irrigation on antimicrobial resistance in the soil microbiome. Water Research 193: 116818. doi: https://doi.org/10.1016/j.watres.2021.116818
- Kampouris ID, Klümper U, Agrawal S, Orschler L, Cacace D, Kunze S, Berendonk TU (2021) Treated wastewater irrigation promotes the spread of antibiotic resistance into subsoil pore-water. Environment International 146: 106190. doi: 10.1016/j.envint.2020.106190
- Kampouris ID, Alygizakis N, Klümper U, Agrawal S, Lackner S, Cacace D, Kunze S, Thomaidis NS, Slobdonik J, Berendonk TU (2021) Elevated levels of antibiotic resistance in groundwater during treated wastewater irrigation associated with infiltration and accumulation of antibiotic residues. Journal of Hazardous Materials, 127155. https://doi.org/10.1016/j.jhazmat.2021.127155
-
Kneis D, Berendonk TU, Forslund SK, Hess S (2022) Antibiotic Resistance Genes in River Biofilms: A Metagenomic Approach toward the Identification of Sources and Candidate Hosts. Environmental Science & Technology. https://doi.org/10.1021/acs.est.2c00370
-
Mishra S, Klümper U, Voolaid V, Berendonk TU, Kneis D (2021) Simultaneous estimation of parameters governing the vertical and horizontal transfer of antibiotic resistance genes. Science of The Total Environment. https://doi.org/10.1016/j.scitotenv.2021.149174.
- Teban-Man A, Farkas A, Baricz A, Hegedus A, Szekeres E, Pârvu M, Coman C (2021) Wastewaters, with or without Hospital Contribution, Harbour MDR, Carbapenemase-Producing, but Not Hypervirulent Klebsiella pneumoniae. Antibiotics 10(4): 361. doi: 10.3390/antibiotics10040361
- Teban-Man A, Szekeres E, Fang P, Klümper U, Hegedus A, Baricz A, Berendonk TU, Pârvu M, Coman C (2022) Municipal wastewaters carry important carbapenemase genes independent of hospital input and can mirror clinical resistance patterns. Microbiology Spectrum e02711-21. https://doi.org/10.1128/spectrum.02711-21
- Wang Y, Yu Z, Ding P, Lu J, Klümper U, Murray A, Gaze W, Guo J (2022) Non-antibiotic pharmaceuticals promote conjugative plasmid transfer at a community-wide level. Microbiome 10, 124. https://doi.org/10.1186/s40168-022-01314-y
- Weise K, Winter L, Fischer E, Kneis D, de la Cruz Barron M, Kunze S, Berendonk TU, Jungmann D, Klümper U (2022) Multiwalled Carbon Nanotubes Promote Bacterial Conjugative Plasmid Transfer. Microbiology Spectrum e00410-22. https://doi.org/10.1128/spectrum.00410-22
-
Zalewska M, Błażejewska A, Czapko A, Popowska M (2021) Antibiotics and Antibiotic Resistance Genes in Animal Manure – Consequences of Its Application in Agriculture. Frontiers in Microbiology 12. https://doi.org/10.3389/fmicb.2021.610656
-
Zhou LJ, Han P, Zhao M, Yu Y, Sun D, Hou L, Liu M, Zhao Q, Tang X, Klümper U, Gu JD, Men Y, Wu QL (2021) Biotransformation of lincomycin and fluoroquinolone antibiotics by the ammonia oxidizers AOA, AOB and comammox: A comparison of removal, pathways, and mechanisms. Water Research 196: 117003. https://doi.org/10.1016/j.watres.2021.117003

© Felix Grunicke

© Felix Grunicke

© Felix Grunicke
Downloads

© Agata Goryluk

© Giulia Gionchetta

© Giulia Gionchetta
For the website content the author is responsible.